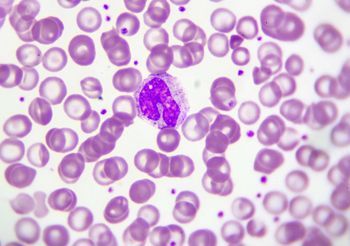
Monocyty to grupa białych krwinek. Na zdjęciu monocyty w rozmazie krwi obwodowej, barwienie metodą Wrighta.

Test HIV Simplitude ByMe, 1 sztuka
WYRÓB MEDYCZNY, Produkt dostępny bez recepty
Dostępność:
Produkt został wycofany z oferty
-
Popularne
-
Inne produkty z kategorii
-
Ostatnio oglądane
-
Popularne produkty
2 600 punktów odbioru
Odbierz zamówienie w wybranej aptece
20 tys. produktów
Szeroki asortyment produktów
Darmowa dostawa w 24 h
Szybka i darmowa dostawa do apteki
Opis
HIV test Simplitude ByMe to immunochromatograficzny, szybki test wykrywający przeciwciała przeciwko ludzkiemu wirusowi niedoboru odporności typu 1 (HIV-1) i typu 2 (HIV-2) w krwi.
Test HIV do samodzielnego wykonania jest przeznaczony do stosowania w warunkach domowych. Urządzenie typu „all in one” - nakłuwacz i pipeta do pobrania krwi wbudowane są w urządzenie testowe. Wynik testu po 15 minutach. Dokładność na poziomie 99,6%.
Działanie
Istnieją 2 typy ludzkiego wirusa niedoboru odporności (HIV): HIV-1 i HIV-2. Układ odpornościowy osoby zarażonej wirusem HIV-1 lub HIV-2 wytwarza przeciwciała przeciwko jednemu, drugiemu lub obu typom wirusa.
HIV test Simplitude ByMe jest przeznaczony do wykrywania przeciwciał w ludzkiej krwi, które pojawiają się w wyniku infekcji któregokolwiek z typów wirusa. W przypadku uzyskania wyniku pozytywnego, musi on zostać potwierdzony przez lekarza na podstawie dalszych badań.
Sposób użycia
Test ma wbudowany sterylny lancet do nakłucia palca i pozyskania próbki krwi. Zielona nasadka zapewnia sterylność lancetu przed użyciem. Test wykonuje się poprzez umieszczenie niewielkiej kropli krwi na pasku testowym (w dołku), a następnie naniesienie 4 kropli płynu testowego (diluent). Kiedy test jest zakończony, na pasku testowym mogą pojawić się dwie linie. Widoczna linia kontrolna wskazuje, że diluent został dodany i migrował pomyślnie a odczynniki testowe działają prawidłowo. Linia testowa stanie się widoczna tylko wtedy, gdy dodana próbka będzie zawierać przeciwciała przeciwko HIV.
Ostrzeżenia
To jest wyrób medyczny. Używaj go zgodnie z instrukcją używania lub etykietą.
- Jest jest przeznaczony wyłącznie do jednorazowego użytku.
- Nie używać testu ponownie.
- Wszystkie pozytywne wyniki testów muszą zostać potwierdzone przez lekarza lub uprawnionego pracownika służby zdrowia.
- Test należy przechowywać w temperaturze od 2°C do 30°C.
- Nie otwieraj foliowego opakowania, aż nie będziesz gotowy do wykonania testu. Ogrzej saszetkę do temperatury pokojowej, zużyj od razu po otwarciu.
Zawartość
- 1 x Test HIV do samodzielnego wykonania
- 2 x Prosta, czytelna instrukcja
- 1 x Butelka z płynem testowym
- 1 x Dyskretny worek na odpady
- 1 x Opatrunek samoprzylepny
- 1 x Karta wsparcia
Sposób przechowywania: 15°C - 25°C
Producent: ZBADAJSIE
Pozwolenie: DOC*
Kod EAN: 9349609000204
To jest wyrób medyczny. Używaj go zgodnie z instrukcją używania lub etykietą.